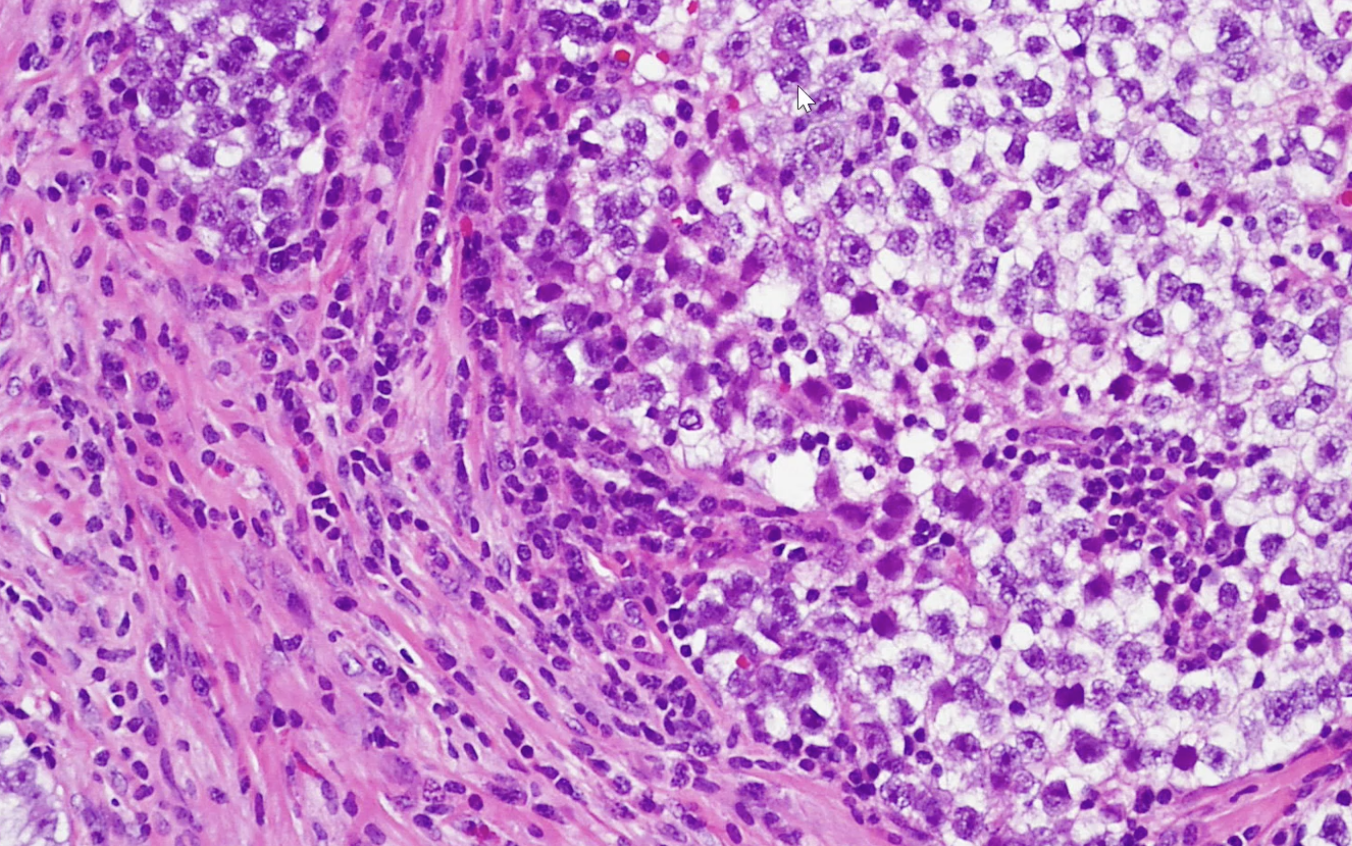
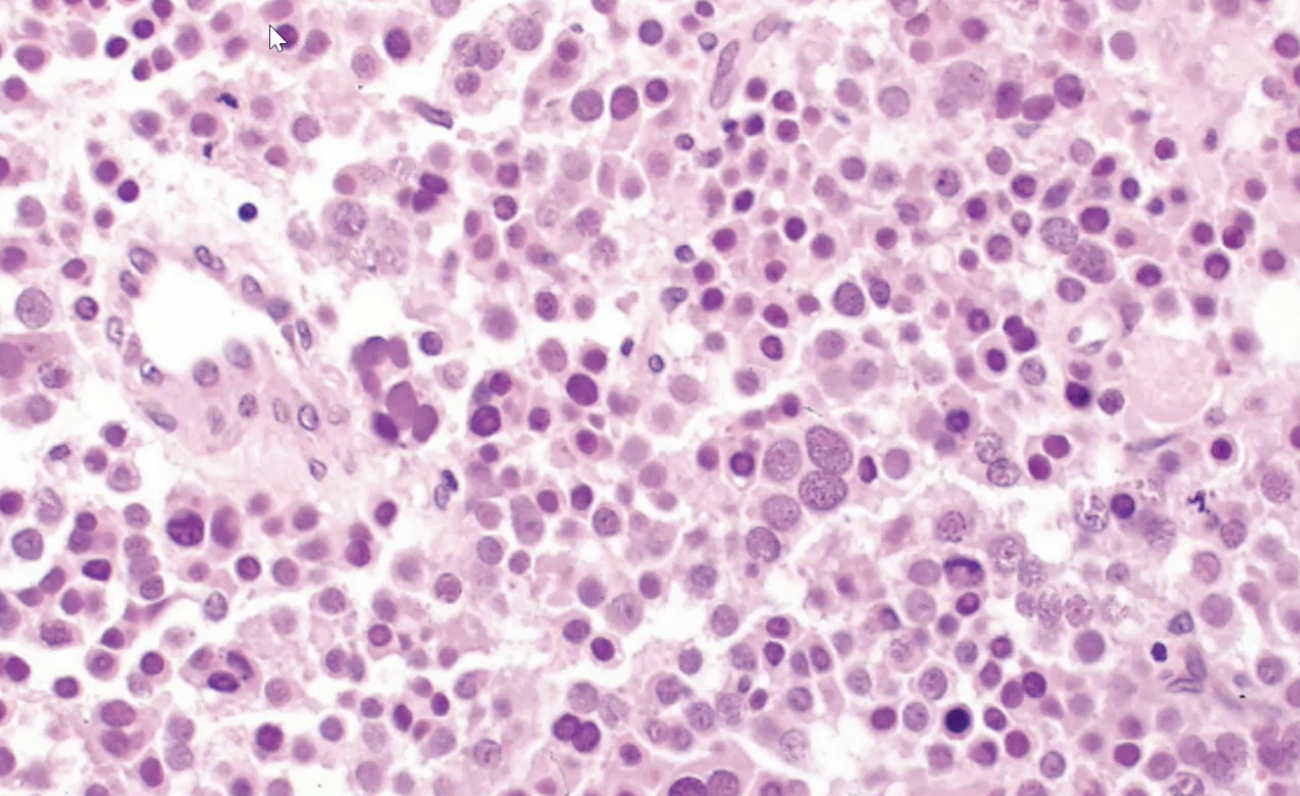
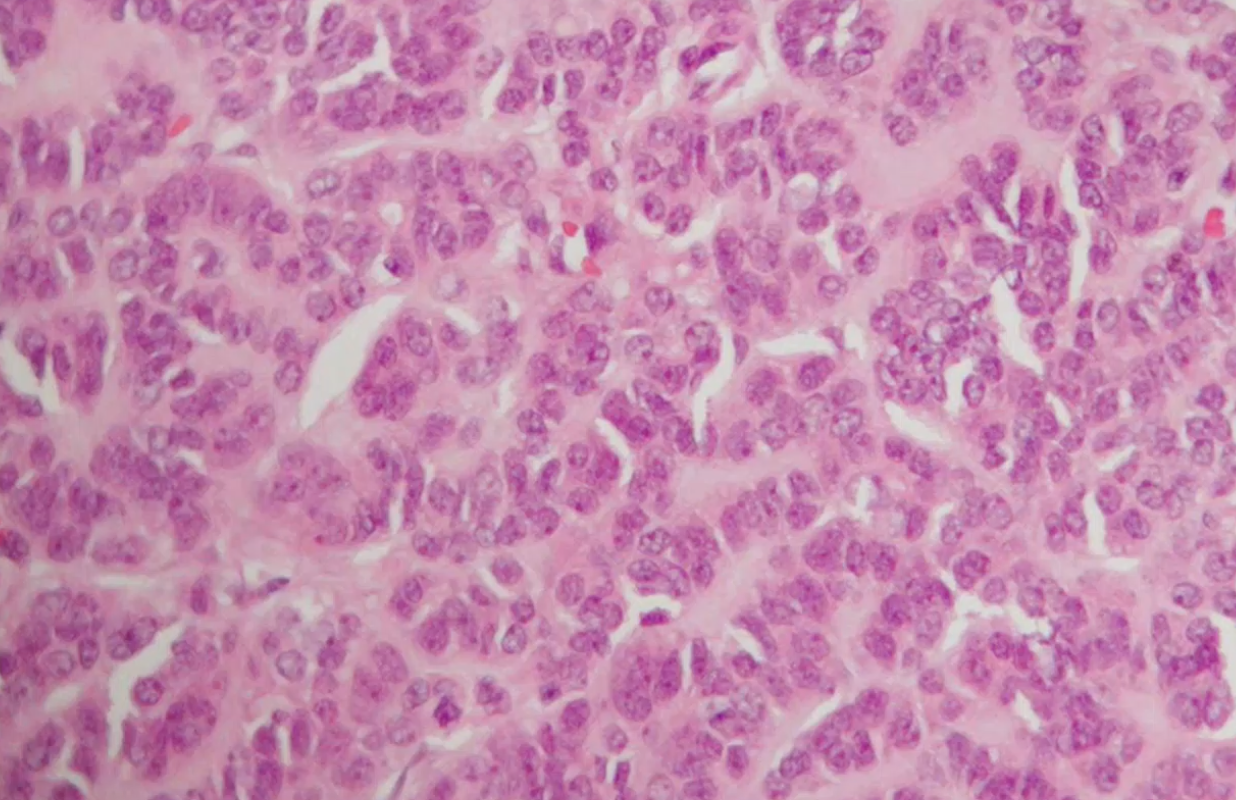

1/54
3 Q's: 2 Q's Lecture, 1 Q Lab
Name | Mastery | Learn | Test | Matching | Spaced | Call with Kai |
|---|
No study sessions yet.
Cryptochordism
Impaired descent of testes, usually unilateral, 5-10x increased risk of germ cell tumors
Orchiopexy
Surgical repair of cryptochordism
Two types of testicular torsion
Testicular torsion - twisting of the spermatic cord
Appendix testes torsion - twisting of remnant mullerian duct
Bellclapper Deformity
Tunica vaginalis completely encompasses the epididymus and testes

Testicular torsion

Testicular Torsion
Klinefelter syndrome
47XXY, testicular atrophy , gynecomastia and learning difficulties

Testicular Atrophy

Testicular Atrophy; Increased leyding cells

Acute orchitis

Acute Orchitis
Viral causes of orchitis
Coxsackie and mumps

Tuberculosis Orchitis
Noninfectious, unilateral scrotal enlargement in older men often mistaken for neoplasm
Granulomatous Orchitis

Granulomatous Orchitis

Granulomatous orchitis
Most common type of testicular tumor
germ cell tumor (15-35 yo men)
Germ cell tumor genetic deficiency
Isochrome 12P
Germ Cell Tumors and Lab Markers
Beta-HCG - Choriocarcinoma
Alpha Fetoprotein.- Yolk Sac
LDH - Above + Seminoma

Seminoma - 30-40 yo men and good prognosis

Seminoma

Seminoma
Seminoma

PLAP stain Seminoma

Embryonal Carcinoma - puberty to age 30 worse prognosis than seminoma

Embyronal Carcinoma

Yolk Sac - 16 to 17 mo old. Elevated serum AFP 20% of children may have metastasis

Microcystic Yolk Sac Tumor

Schiller-Duval Body Yolk Sac

Hyaline globules of yolk sac tumor

Choriocarcinoma - 25 to 30 years old , elevated B HCG, likes to metastasize early

Choriocarcinoma
Teratoma most important history:
Before or after puberty. After puberty much more likely to be malignant.

Teratoma

Mature teratoma - better prognosis

Immature teratoma - worse prognosis
Spermatocytic Tumor - Male 70 yo

Leydig Cell Tumor

Leydig Cell Tumor
Unique histology feature of leydig cell tumor
Reinke crystal

Sertoli cell tumor
Sertoli cell tumor
Gonadoblastoma
Also happens with chromosome mosaicism (45X and 46XY) , half of these turn into seminoma

Testicular Lymphoma

Hydrocele
Vastitis Nodosa
Vas deferens reacts to vasectomy

Hydrocele

Testicular Atrophy

Testicular Torsion

Seminoma

Seminoma

Teratoma

Yolk sac tumor

Lymphoma

Embryonal Carcinoma